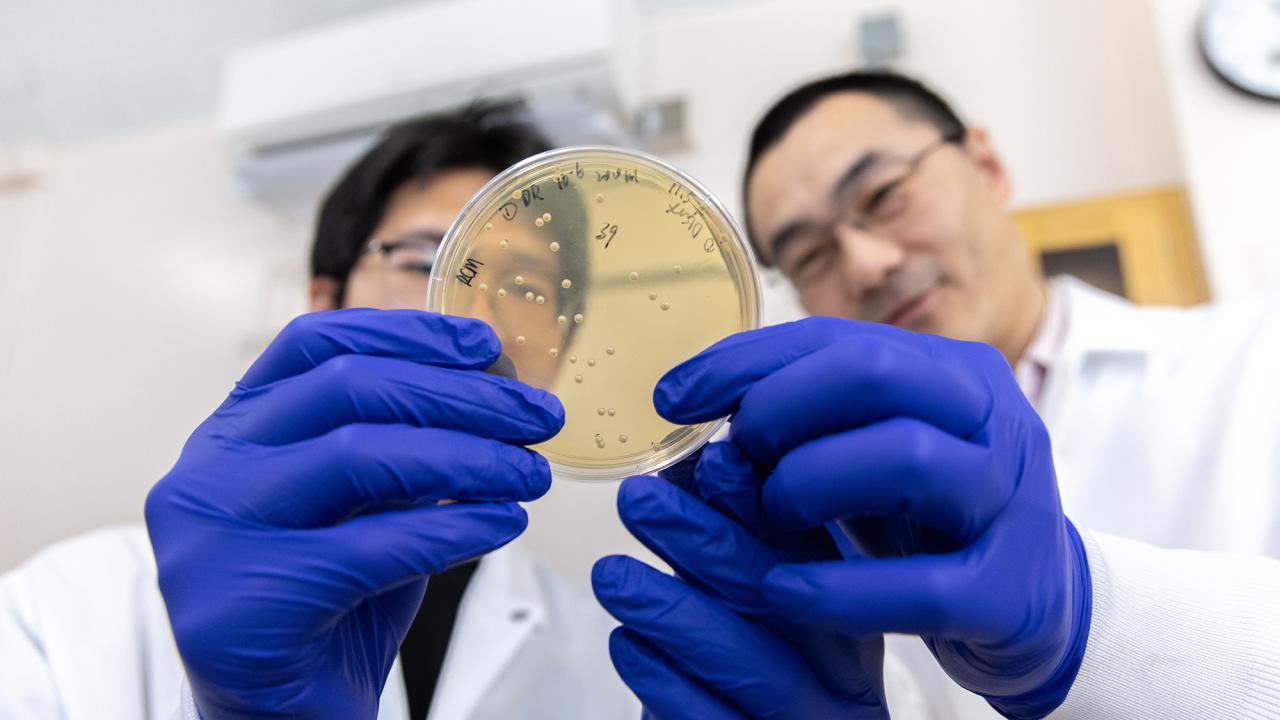
Two people wearing white lab coats and blue vinyl gloves hold a petri dish in front of the camera. Their faces are slightly out of focus.

A new federally funded research project at the University of California, Davis, endeavors to extract valuable components for magnets, lasers and other modern technologies from an unlikely source: acidic wastewater from mines and industrial processes.
The U.S. Department of Energy’s Advanced Research Projects Agency-Energy (ARPA‑E) awarded UC Davis researchers a $3 million grant to develop a bio‑based process that selectively captures rare earth elements from acidic mine‑influenced and industrial wastewater streams. The project is led by Yi Wang, an assistant professor in the Department of Biological and Agricultural Engineering.
Rare earth elements are essential for high‑efficiency permanent magnets in electric vehicles, wind turbines and advanced electronics. Yet, conventional extraction and separation methods are chemically intensive and generate significant waste. The UC Davis‑led team aims to transform this by engineering acid‑tolerant microbes to produce metal‑binding proteins that work directly at low pH, enabling low-cost onsite recovery.
“This technology aims to turn a liability into a resource,” said Wang. “By selectively capturing rare earths where acidic wastewater is generated — like acid mine drainage and tailings liquors — we can reduce chemical use and waste while strengthening a resilient domestic supply chain for clean‑energy manufacturing.”
The project aims to use artificial intelligence for protein design, structural characterization and acid‑compatible process development. Engineered biocatalysts, deployed in acid-tolerant microbial hosts, will selectively capture rare earth elements from acidic wastewaters, delivering a simpler, cleaner route from dilute waste streams to valuable materials.
Molecular precision
“Our AI‑guided protein design lets us tune the protein binding loops to remain fast and highly selective even at very low pH,” said Justin Siegel, co‑principal investigator and professor in the Department of Chemistry. “That molecular precision — coupled with acid-tolerant microbes — enables a shorter, greener recovery train with fewer unit operations.”
The UC Davis‑led ARPA‑E project hopes to demonstrate selective, low‑pH recovery and onsite concentration of critical rare earth elements from difficult wastewaters — reducing chemicals and energy, shrinking waste, and tapping large domestic inventories that are currently discarded.
In addition to the core science, the project includes a dedicated tech‑to‑market effort to chart a path from lab discovery to real‑world deployment. “Our job is to make sure this doesn’t stay just a great idea on paper,” said Boon‑Ling Yeo, co‑principal investigator and lead for the tech‑to‑market task at UC Davis. “We’re evaluating costs, markets and potential partners so that recovering rare earths from wastewater is not only technically feasible, but also economically attractive for utilities, mining operators and manufacturers across the United States.”
Besides UC Davis investigators, the project collaborators include Libin Ye from the University of South Florida, and Ning Sun and Chang Dou from Lawrence Berkeley National Laboratory.
The Proposal Development Services team within the Office of Research played an instrumental role to help create a successful proposal for the ARPA-E award. The team offers extensive services and resources to assist in the development and submission of extramural funding proposals.
About ARPA-E
The UC Davis project is part of a $25 million investment to develop technologies that recover previously discarded critical minerals from U.S. wastewaters. As part of a critical minerals and materials funding initiative announced by the Department of Energy earlier this year, the Realize Energy-rich Compound Opportunities Valorizing Extraction from Refuse waters (RECOVER) program aims to reduce American dependence on critical mineral imports by establishing new, secure, domestic supply chains.
Media Resources
Energy Department Announces $25 Million to Extract Critical Minerals from Wastewater (ARPA-E Announcement)
Video: Reprogramming Microbes for a Cleaner Tomorrow
Media Contacts
- Yi Wang, Biological and Agricultural Engineering, vipwang@ucdavis.edu
- Andy Fell, News and Media Relations, 530-304-8888, ahfell@ucdavis.edu
Neelanjana Gautam is a communications specialist with the UC Davis Office of Research.